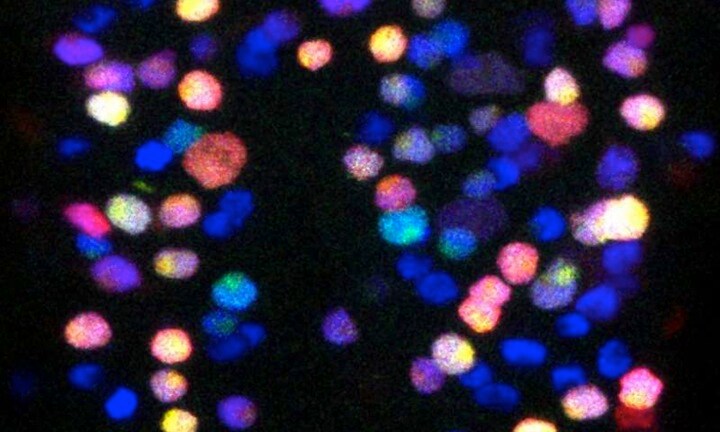
ショウジョウバエの脳の幹細胞。緑色/赤色/黄色が新しいニューロンを生成している　Credit: Andrea Brand/Leo Otsuki

<ケンブリッジ大学の研究者が、再生能力を持つ脳の休止幹細胞を発見。脳の自己治癒力を高める方法が存在する可能性が出てきた>
脳は、自己治癒力に乏しく、かつては、脳卒中やアルツハイマー病などによって一度損傷を受けると再生しないと考えられていた。しかし、昨今、脳科学の進歩によって、損傷された脳を修復する、いわゆる再生医学の研究が、積極的にすすめられている。
そして、このほど、細胞の自己複製能力と別の種類の細胞に分化する能力を合わせもつ「幹細胞」のなかに、脳の損傷や疾患から再生する力を持つものが存在することがわかった。
高い再生能力を持つ、新たな脳の休止幹細胞を発見
英ケンブリッジ大学ガードン研究所の研究プロジェクトは、2018年4月、学術雑誌「サイエンス」において、既知のものよりも高い再生能力を持つ、新たな脳の休止幹細胞を発見したことを報告した。
G2期(細胞周期における分裂前準備期)で休止状態になっているこの幹細胞は、活性化されると、脳の神経細胞や神経膠細胞において重要な細胞を、既知の幹細胞よりも速く生成するのが特徴だ。
幹細胞は、脳のあらゆる細胞を生成する能力を有するが、通常は、休止状態にあり、新しい細胞を増殖させたり、生成したりすることはない。従って、幹細胞に働きかける再生医療においては、まず、幹細胞を休止状態から活性化させることが不可欠なのである。

休止幹細胞を制御する遺伝子に働きかける
そこで、研究プロジェクトは、ヒトのDNAとよく似ており、疾病に関連するヒトの遺伝子の60%が存在するショウジョウバエを使って、G2期で休止状態となっている幹細胞を制御する「Trbl」という遺伝子を特定し、この遺伝子がG2期にある神経幹細胞を休止状態へと誘っていることを明らかにした。